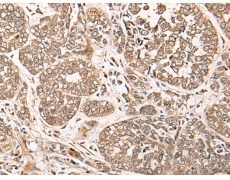
一抗

中文名稱:兔抗CA5B多克隆抗體
|
Background: |
Carbonic anhydrases (CAs) are a large family of zinc metalloenzymes that catalyze the reversible hydration of carbon dioxide. They participate in a variety of biological processes, including respiration, calcification, acid-base balance, bone resorption, and the formation of aqueous humor, cerebrospinal fluid, saliva, and gastric acid. They show extensive diversity in tissue distribution and in their subcellular localization. CA VB is localized in the mitochondria and shows the highest sequence similarity to the other mitochondrial CA, CA VA. It has a wider tissue distribution than CA VA, which is restricted to the liver. The differences in tissue distribution suggest that the two mitochondrial carbonic anhydrases evolved to assume different physiologic roles. |
|
Applications: |
ELISA, IHC |
|
Name of antibody: |
CA5B |
|
Immunogen: |
Synthetic peptide of human CA5B |
|
Full name: |
carbonic anhydrase 5B |
|
Synonyms: |
CA-VB |
|
SwissProt: |
Q9Y2D0 |
|
ELISA Recommended dilution: |
5000-10000 |
|
IHC positive control: |
Human esophagus cancer |
|
IHC Recommend dilution: |
50-300 |

 購物車
購物車 幫助
幫助
 021-54845833/15800441009
021-54845833/15800441009